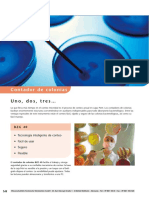

INSTRUCCIONES DE OPERACIÓN
INSTRUCCIONES
DE OPERACIÓN
ba77090s02 01/2017
®
SenTix HW-T 900(-P)
SONDA DE MEDICIÓN pH CON SISTEMA LÍQUIDO DE REF. ET DIAFRAGMA ESMERILADO
� SenTix®HW-T 900(-P)
Copyright © 2017, Xylem Analytics Germany GmbH
Printed in Germany.
2 ba77090s02 01/2017
�SenTix®HW-T 900(-P) Información general
1 Información general
Reconocimiento EEn el cabezal del electrodo se encuentra la electrónica sensora con los
automático del datos archivados del sensor. Estos datos incluyen, entre otros, el tipo del
sensor sensor y el número de serie. Además, en el sensor se guardan los datos de
calibración de cada calibración, registrando así el historial de calibración (las
últimas 10 calibraciones). Al conectar el sensor al instrumento de medición,
éste llama los datos y los pone a disposición para la medición, asimismo los
utiliza para documentar la medición.
Gracias a que los datos de calibración se encuentran archivados en el
sensor, al trabajar con diferentes instrumento de medición, se aplica automá-
ticamente para cada caso en particular, la pendiente y la asimetría correctas.
Y a la inversa, en un sólo instrumento de medición se pueden emplear dife-
rentes sensores calibrados sin necesidad de tener que calibrar nuevamente.
La técnica de transmisión digital permite la comunicación sin perturbación
alguna con el instrumento de medición, aún si los cables de conexión son
muy largos. La firmware del sensor puede ser actualizada, a través del
instrumento de medición.
Refuerzo de Para proteger el electrodo contra efectos mecánicos se puede colocar el
protección refuerzo de protección A 925-P/K (con canastilla protectora de plástico), o
A 925-P/K y A 925- bien el A 925-P/S (con canastilla protectora de acero), y quitarlo posterior-
P/S (accesorio) mente. El tipo de canastillo de acero sirve además de lastre para efectuar
mediciones a gran profundidad.
ba77090s02 01/2017 3
�Información general SenTix®HW-T 900(-P)
2 Puesta en funcionamiento, medición,
calibración
2.1 Abrir y cerrar la conexión de enchufe IDS
Este párrafo se refiere únicamente a conexiones de enchufe de la variante
IDS (SenTix® ... -P).
Conexión de enchufe
cerrada y bloqueada
4 1
3 2
Guía
Ranura
Abrir la conexión Limpiar la conexión de enchufe en caso necesario.
de enchufe Abrir el mecanismo de bloqueo (paso 1).
Oprimir con el pulgar y dedo índice las pestañas de acople y sacar el
acople del enchufe (paso 2).
Cerrar la conexión Preste atención que la conexión de enchufe esté completamente limpia y
de enchufe seca.
Orientar la guía del acople con la ranura del enchufe e introducir el acople
en el enchufe liberado, hasta que encaje (paso 3).
Cerrar el mecanismo de bloqueo (paso 4).
4 ba77090s02 01/2017
�SenTix®HW-T 900(-P) Información general
2.2 Puesta en funcionamiento
Partes incluídas Sonda de medición SenTix®HW-T 900(-P)
Instrucciones de operación
Puesta en La sonda de medición ha sido llenada en la fábrica con la solución electrolí-
funcionamiento tica de referencia. Prepare la sonda de la siguiente manera para comenzar
con la medición:
Abra el agujero de llenado para la solución electrolítica de referencia.
Dependiendo del tipo de sonda, el cierre del agujero de llenado puede ser
un tapón elastómero o bien, una corredera.
¡El agujero de llenado tiene que estar siempre abierto durante la cali-
bración y durante la medición!
agujero
agujero de llenado
de llenado
1
2
Quite la cubierta de remoje de la punta del electrodo. Eventuales incrus-
taciones de sal en la zona de la cubierta de remoje no influyen las carac-
terísticas de medición y pueden ser eliminadas fácilmente con agua
desionizada.
Guarde la cubierta de remoje. Es necesaria para el almacena-
miento de la sonda de medición. Mantenga siempre limpia la
cubierta de remoje.
Conecte la sonda de medición al instrumento de medición
Calibre la sonda de medición de acuerdo al manual de instrucciones del
instrumento. Observe además las regulaciones generales en la página
siguiente.
Diafragma En el diafragma esmerilado del electrodo de medición SenTix®HW-T 900(-
esmerilado P), el flujo del electrolito es regulado por medio de una rosca:
SenTix®HW- Mantenga la sonda de medición con la membrana pH de vidrio hacia
T 900(-P) abajo y abra el esmerilado mediante la llave especial adjunta, hasta que
del esmerilado salga visiblemente solución electrolítica y el esmerilado
quede completamente mojado.
ba77090s02 01/2017 5
�Información general SenTix®HW-T 900(-P)
diafragma esmerilada
cerrar abrir
llave especial
Cierre ahora el esmerilado cuidadosamente y sin ejercer fuerza, hasta
que note la resistencia de fricción entre las superficies esmeriladas áspe-
ras. La sonda de medición está ahora lista para medir.
OBSERVACION
Cuidado: Nunca cierre el diafragma ejerciendo fuerza, para no dete-
riorar el esmerilado!
Para aumentar el flujo del electrolito, abrir más el esmerilado.
Establecer la SenTix®HW-T 900 Conecte el sensor al instrumento de medición.
disposición para El sensor está inmediatamente en condiciones de
medir del funcionamiento, listo para medir.
instrumento
SenTix®HW-T 900-P Conecte el sensor con un enchufe de acopla-
miento IDS libre de la sonda de parámetro múltiple
o bien, con una conexión IDS del instrumento de
medición. Para abrir y cerrar la conexión de
enchufe IDS, vea el párrafo 2.1 ABRIR Y CERRAR LA
CONEXIÓN DE ENCHUFE IDS.
El sensor está inmediatamente en condiciones de
funcionamiento, listo para medir.
Respecto a los cables de conexión en diferentes
longitudes para conectar el sensor SenTix®HW-
T 900-P al instrumento de medición, consulte el
capítulo 7 PIEZAS DE DESGASTE Y ACCESORIOS.
2.3 Calibrar y medir: Reglas generales
Preste atención que el agujero de llenado de la solución electrolítica de
referencia esté abierto.
Evite arrastrar o transportar residuos de solución (de solución de medi-
ción o solución tamponada) de una medición a otra, adoptando las
siguientes medidas preventivas:
– Enjuague los envases de las muestras y los recipientes de calibración
con la solución que pretende llenar a continuación.
6 ba77090s02 01/2017
�SenTix®HW-T 900(-P) Almacenamiento
– Enjuague la sonda entre cada medición con la solución que va a usar
en el siguiente paso. Como alternativa puede enjuagar la sonda de
medición con agua desionizada, secándola a continuación con cui-
dado.
Sumerja la sonda de medición verticalmente en la solución, o bien, ligera-
mente inclinada.
Preste atención de sumerjir la sonda a la profundidad de inmersión
correcta. El diafragma esmerilado debe quedar completamente sumer-
gido en la solución. Además, el nivel del electrolito de referencia debe
quedar por lo menos 2 cm sobre el nivel de la solución.
Al agitar la solución durante la medición, establezca aproximadamente las
mismas condiciones que durante la calibración.
Calibraciones La frecuencia con que se llevan a cabo las calibraciones subsecuentes
siguientes depende de la aplicación. Muchos instrumentos de medición permiten confi-
gurar el intervalo de calibración. Luego que el intervalo de calibración ha
transcurrido, el instrumento le recuerda automáticamente el plazo para la
siguiente calibración.
3 Almacenamiento
Durante breves Sumerja la sonda de medición con el agujero de llenado abierto en el elec-
interrupciones en trolito de referencia (KCl 3 mol/l, sin Ag+). Preste atención a la profundidad
el transcurso de de inmersión mínima. Enjuague la sonda con la solución de medición o bien,
las mediciones con agua desionizada, antes de la siguiente medición.
Evite el contacto de la membrana pH con el fondo del envase,
para no deteriorarla.
Durante la noche o Introduzca la sonda de medición limpia en la cubierta de remoje llena de
por un período electrolito de referencia (KCl 3 mol/l, sin Ag+) y cierre el agujero de llenado.
más prolongado
OBSERVACION
No secar los electrodos de medición pH ni almacenarlos en agua desio-
nizada. De lo contrario los electrodos pueden ser deteriorados irrepa-
rablemente. Si el líquido de la cubierta de remoje se ha secado,
condicione la sonda de medición durante 24 h en el electrolito de refe-
rencia (KCl 3 mol/l, sin Ag+).
Durante el almacenamiento prolongado se pueden formar
incrustaciones de sal en la cubierta de remoje. Estas incrustacio-
nes no influyen las propiedades de medición y pueden ser elimi-
nadas fácilmente con agua desionizada antes de comenzar con
el trabajo.
ba77090s02 01/2017 7
�Envejecimiento SenTix®HW-T 900(-P)
4 Envejecimiento
Las sondas de medición pH son productos propensos al desgaste. Toda
sonda de medición del pH está expuesta al envejecimiento natural. Así, la
sonda reacciona cada vez con más lentitud y su pendiente y asimetría cam-
bian.
OBSERVACION
No secar los electrodos de medición pH .... De lo contrario los elec-
trodos pueden ser deteriorados irreparablemente.
Ejemplos para condiciones de trabajo más duras:
Ácidos o lejías fuertes, soluciones de ácido fluorhídrico, disolventes orgá-
nicos, aceites, grasas, bromuros, sulfuros, yoduros, proteínas
Altas temperaturas
Cambios bruscos del pH y de la temperatura.
Si el instrumento falla o es deteriorado mecánicamente por trabajar bajo
estas condiciones extremas, se pierde el derecho de garantía.
5 Mantenimiento y limpieza
Rellenar electrolito Es normal que durante el funcionamiento escape electrolito de referencia en
de referencia cantidades pequeñas de la sonda de medición a través del diafragma, escu-
rriendo hacia la solución de medición. Si con el tiempo el nivel cae excesiva-
mente, rellene electrolito de referencia a través del agujero de llenado.
Utilizando la botella adjunta con su boquilla de gotera resulta muy fácil relle-
nar electrolito. Proceda de la siguiente manera:
Corte rectamente la punta de la boquilla, hasta que en la punta aparezca
el orificio
Abra el agujero de llenado de la sonda de medición
Oprima la punta de la boquilla con un leve movimiento giratorio y sin ejer-
cer mucha presión en el agujero de llenado
Llene el vástago con electrolito de referencia bombeando la botella
Extraiga la punta de la boquilla del agujero de llenado, girando la botella
ligeramente.
8 ba77090s02 01/2017
�SenTix®HW-T 900(-P) Especificaciones técnicas
Limpieza Elimine impurezas y residuos solubles en agua enjuagando con agua desio-
nizada. Elimine otras impurezas de la siguiente manera:
Impurezas/contaminación Procedimientos de limpieza
Grasas y aceites enjuagar con agua y detergente
Incrustaciones de cal e enjuagar con ácido cítrico (al 10 % en peso)
hidróxido
Proteínas y albúminas sumergir en una solución de pepsina PEP/pH
de limpieza y dejar remojar durante 1 hora
aprox.
Observación: Preste atención que el nivel del
electrolito de referencia se encuentre sobre el
nivel de la solución de limpieza.
Soluciones de ácido fluorhídrico, ácido fosfórico caliente y solu-
ciones altamente alcalinas deterioran la membrana de vidrio.
En caso necesario puede Ud. abrir el diafragma esmerilado para su limpieza,
de la siguiente manera:
Desatornille completamente el núcleo esmerilado (vea la figura en la
página 5).
Después de la Enjuague la sonda de medición con agua desionizada y condicionela
limpieza durante 1 hora en una solución con electrolito de referencia. A continuación
calibre la sonda de medición.
6 Especificaciones técnicas
Características de Rango de medición del pH 0,000 ... 14,000
medición y de Rango de temperatura 0 ... 60 °C
aplicación admisible
ba77090s02 01/2017 9
�Especificaciones técnicas SenTix®HW-T 900(-P)
Exactitud de la Parámetro Exactitud (± 1 dígito)
eléctrónica de pH ± 0,004
medición IDS
U [mV] ± 0,2
T [°C] ± 0,1
Características Electrolito de referencia KCl 3 mol/l, sin+Ag
generales
Diafragma Esmerilado
Sensor térmico NTC 30 integrado
(30 ka 25 °C / 77 °F)
Cable de conexión Longitudes SenTix®HW-T 900: 1,5
SenTix®HW-T 900-P:
1,5 / 3 / 6 / 10 / 15 / 25 / 40 / 60 / 100 m
Diámetro 4,3 mm
Radio mínimo de flexión tendido fijo:20 mm
admisible aplicación libre:60 mm
Tipo de enchufe buje, 4 polos
Dimensiones del Longitud del vástago 170 mm
vástago, material Diámetro del vástago 12 mm
Material del vástago Vidrio
Enchufe IDS Piezas de material sintético: Noryl, TPU,
TPC-ET, POM, PVC, PEEK, PBT, refor-
zados con fibra de vidrio
Anillo O: FPM
Contactos chapados al oro
Enchufe IDS Tipo de conexión Conexión de enchufe, 4 polos, hermética
con mecanismo de bloqueo, segura contra
alteración de la polaridad
Almacenamiento Con cubierta de remoje, llena de KCl 3 mol/l, sin Ag+
10 ba77090s02 01/2017
�SenTix®HW-T 900(-P) Piezas de desgaste y accesorios
7 Piezas de desgaste y accesorios
Productos para el Descripción Modelo No. de
mantenimineto pedido
Solución de electrolito de referencia 250 ml KCl-250 109 705
(KCl 3 mol/l, sin Ag+)
Solución de limpieza de pepsina 3 x 250 ml PEP/pH 109 648
Cable de conexión Descripción Modelo No. de
SenTix®HW- pedido
T 900(-P) - Cable de conexión IDS, 1,5 m AS/IDS-1.5 903 850
instrumento de Cable de conexión IDS, 3 m AS/IDS-3 903 851
medición
Cable de conexión IDS, 6 m AS/IDS-6 903 852
Cable de conexión IDS, 10 m AS/IDS-10 903 853
Cable de conexión IDS, 15 m AS/IDS-15 903 854
Cable de conexión IDS, 20 m AS/IDS-20 903 855
Cable de conexión IDS, 25 m AS/IDS-25 903 856
Cable de conexión IDS, 40 m AS/IDS-40 903 857
Cable de conexión IDS, 60 m AS/IDS-60 903 858
Cable de conexión IDS, 100 m AS/IDS-100 903 859
Accesorios en Descripción Modelo No. de
general pedido
Tapón para el enchufe IDS BPO/IDS 900 908 371
Refuerzo de protección sin canastillo de pro- A 925-P 903 838
tección
Refuerzo de protección con canastilla de A 925-P/K 903 839
plástico
Refuerzo de protección con canastilla de A 925-P/S 903 840
acero
Armadura de plástico para SenTix®HW- A pHLab/K 903 841
T 900(-P) Electrodos para pH
8 Eliminación de materiales residuales
Al término de la vida útil de la sonda de medición, elimínelo ateniéndose a
las directivas de eliminación y/ recolección de resíduos, vigentes en su país
(chatarra electrónica). En caso de dudas, consulte a su comerciante.
ba77090s02 01/2017 11
�Eliminación de materiales residuales SenTix®HW-T 900(-P)
12 ba77090s02 01/2017
��¿Qué puede hacer Xylem por Usted?
Somos un equipo global unido por un propósito común: crear soluciones
innovadoras para satisfacer las necesidades de agua de nuestro mundo.
Desarrollar nuevas tecnologías que mejorarán la manera en que se usa, se conserva y
se reutiliza el agua en el futuro es un aspecto crucial de nuestra labor. Transportamos,
tratamos, analizamos y retornamos el agua al medio ambiente, y ayudamos a las
personas a usar el agua de manera eficiente, en sus casas, edificios, fábricas y campos.
Desde hace mucho tiempo y en más de 150 países, tenemos relaciones sólidas con
clientes que nos conocen por nuestra potente combinación de marcas de producto
líderes y conocimientos de aplicación, con el respaldo de nuestro legado de
innovación.
Para obtener más información, visite xyleminc.com.
Dirección de la asistencia técnica:
Xylem Analytics Germany
Sales GmbH & Co. KG
WTW
Dr.-Karl-Slevogt-Str. 1
82362 Weilheim
Germany
Tel.: +49 881 183-325
Fax: +49 881 183-414
E-Mail wtw.rma@xyleminc.com
Internet: www.WTW.com
Xylem Analytics Germany GmbH
Dr.-Karl-Slevogt-Str. 1
82362 Weilheim
Germany